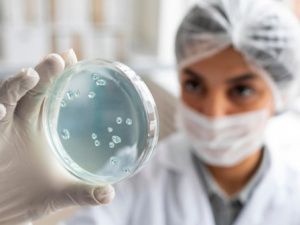
В Якутии снизилась заболеваемость по 17 инфекциям

Лента новостей
03.03.2026 г.
Происшествия
03.03.2026 г.
Столица
03.03.2026 г.
Происшествия
03.03.2026 г.
Происшествия
03.03.2026 г.
Происшествия
03.03.2026 г.
Общество
03.03.2026 г.
Происшествия
03.03.2026 г.
Желтые хроники
03.03.2026 г.
Происшествия
02.03.2026 г.
Желтые хроники
02.03.2026 г.
Культура
02.03.2026 г.
Столица
02.03.2026 г.
Общество
Общество
27.02.2026 12:59 В Якутии снизилась заболеваемость по 17 инфекциям
27.02.2026 12:57 Прокурор Якутии выслушал обращения жителей республики
27.02.2026 11:30 Численность авиадесантников в Якутии вырастет до 848 человек
27.02.2026 00:21 РБК: сроки блокировки Telegram определились
26.02.2026 22:59 Гороскоп для всех знаков Зодиака на 27 февраля 2026 года
26.02.2026 20:20 Ветеран СВО Никифор Кейметинов начал карьеру в лесной отрасли
26.02.2026 18:05 автра на Ленских столбах будет включена ночная подсветка!
26.02.2026 14:15 КТО ИЗ ЯКУТЯН РУКОВОДИЛ СТРОИТЕЛЬСТВОМ ШАХТЫ В МАЛИ?
26.02.2026 12:50 Половина века молодого города - начало великой истории
26.02.2026 12:09 Иммунодефицит у детей в Якутии: цифры, причины и симптомы
26.02.2026 12:03 С 1 марта повышается стоимость въездной визы в Египет
26.02.2026 12:00 «Сели, выпили, труп»
26.02.2026 10:59 «Для солдата его первый бой является самым трудным»
25.02.2026 23:41 До -5 градусов потеплеет в Якутии 26 февраля
Реклама на сайте
Прогноз погоды
Топ-10 за месяц
Интервью недели
Реклама на сайте
Подписаться на новости
Получайте самые свежие и актуальные новости от SakhaTime!
Управление рассылкамиНаши Партнёры
Реклама на сайте
В материалах сетевого издания возможны упоминая иноагентов и запрещенных организаций. Список иноагентов опубликован на сайте https://minjust.gov.ru/uploaded/files/reestr-inostrannyih-agentov-01032024.pdf. Список пополняется.
Список запрещенных организаций опубликован на сайте https://minjust.gov.ru/ru/documents/7822/
Instagram и Facebook (Metа) запрещены в РФ за экстремизм.